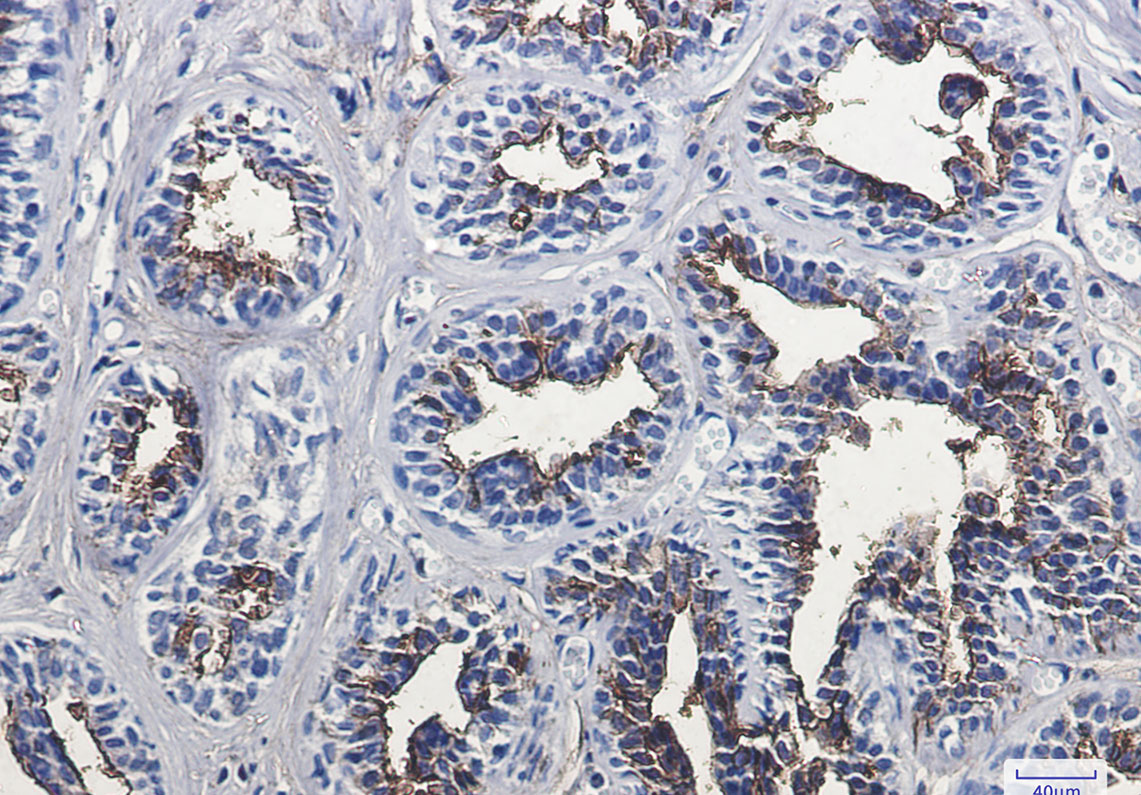
8 - CD13 Rabbit mAb AP74875

CD13 Rabbit mAb
- 产品详情
- 实验流程
- 背景知识
Application
| WB, IHC-P, IHC-F, IP |
|---|---|
| Primary Accession | P15144 |
| Reactivity | Rat, Human |
| Host | Rabbit |
| Clonality | Monoclonal Antibody |
| Isotype | IgG |
| Conjugate | Unconjugated |
| Purification | Affinity Purified |
| Calculated MW | 109540 Da |
| Gene ID | 290 |
|---|---|
| Other Names | ANPEP |
| Dilution | WB~~1:1000-1:5000 IHC-P~~1:50~200 IHC-F~~N/A IP~~1:10-1:100 |
| Format | Liquid in 50mM Tris-Glycine(pH 7.4), 0.15M NaCl, 40%Glycerol, 0.01% sodium azide and 0.05% BSA. |
| Storage | Store at 4°C short term. Aliquot and store at -20°C long term. Avoid freeze/thaw cycles. |
| Name | ANPEP |
|---|---|
| Synonyms | APN, CD13, PEPN |
| Function | Broad specificity aminopeptidase which plays a role in the final digestion of peptides generated from hydrolysis of proteins by gastric and pancreatic proteases. Also involved in the processing of various peptides including peptide hormones, such as angiotensin III and IV, neuropeptides, and chemokines. May also be involved the cleavage of peptides bound to major histocompatibility complex class II molecules of antigen presenting cells. May have a role in angiogenesis and promote cholesterol crystallization. May have a role in amino acid transport by acting as binding partner of amino acid transporter SLC6A19 and regulating its activity (By similarity). |
| Cellular Location | Cell membrane; Single-pass type II membrane protein. Note=Also found as a soluble form |
| Tissue Location | Expressed in epithelial cells of the kidney, intestine, and respiratory tract; granulocytes, monocytes, fibroblasts, endothelial cells, cerebral pericytes at the blood-brain barrier, synaptic membranes of cells in the CNS. Also expressed in endometrial stromal cells, but not in the endometrial glandular cells. Found in the vasculature of tissues that undergo angiogenesis and in malignant gliomas and lymph node metastases from multiple tumor types but not in blood vessels of normal tissues. A soluble form has been found in plasma. It is found to be elevated in plasma and effusions of cancer patients. |
For Research Use Only. Not For Use In Diagnostic Procedures.
Provided below are standard protocols that you may find useful for product applications.
BACKGROUND
CD13 is a 150-170 kD type II transmembrane glycoprotein also known as aminopeptidase N, APN, and gp150. This zinc metallopeptidase is expressed as a homodimer on granulocytes, myeloid progenitors, endothelial cells, epithelial cells and subset of granular lymphoid cells. It is not expressed on platelets or erythrocytes. CD13 is thought to be involved in the metabolism of many regulatory peptides and functions in antigen processing and the cleavage of chemokines such as MIP-1. CD13 serves as the cellular receptor for Coronavirus.
终于等到您。ABCEPTA(百远生物)抗体产品。
点击下方“我要评价 ”按钮提交您的反馈信息,您的反馈和评价是我们最宝贵的财富之一,
我们将在1-3个工作日内处理您的反馈信息。
如有疑问,联系:0512-88856768 tech-china@abcepta.com.























 癌症的基本特征包括细胞增殖、血管生成、迁移、凋亡逃避机制和细胞永生等。找到癌症发生过程中这些通路的关键标记物和对应的抗体用于检测至关重要。
癌症的基本特征包括细胞增殖、血管生成、迁移、凋亡逃避机制和细胞永生等。找到癌症发生过程中这些通路的关键标记物和对应的抗体用于检测至关重要。 为您推荐一个泛素化位点预测神器——泛素化分析工具,可以为您的蛋白的泛素化位点作出预测和评分。
为您推荐一个泛素化位点预测神器——泛素化分析工具,可以为您的蛋白的泛素化位点作出预测和评分。 细胞自噬受体图形绘图工具为你的蛋白的细胞受体结合位点作出预测和评分,识别结合到自噬通路中的蛋白是非常重要的,便于让我们理解自噬在正常生理、病理过程中的作用,如发育、细胞分化、神经退化性疾病、压力条件下、感染和癌症。
细胞自噬受体图形绘图工具为你的蛋白的细胞受体结合位点作出预测和评分,识别结合到自噬通路中的蛋白是非常重要的,便于让我们理解自噬在正常生理、病理过程中的作用,如发育、细胞分化、神经退化性疾病、压力条件下、感染和癌症。